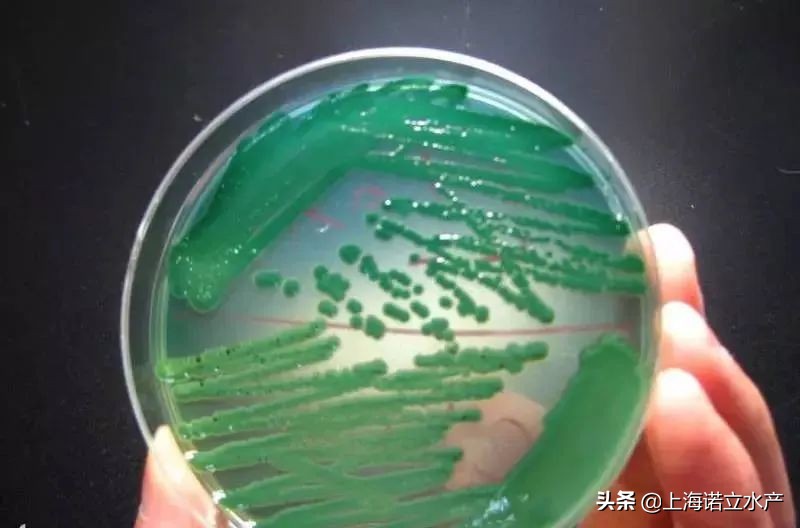
如何判断虾有没有弧菌了,为什么养虾弧菌越杀越多
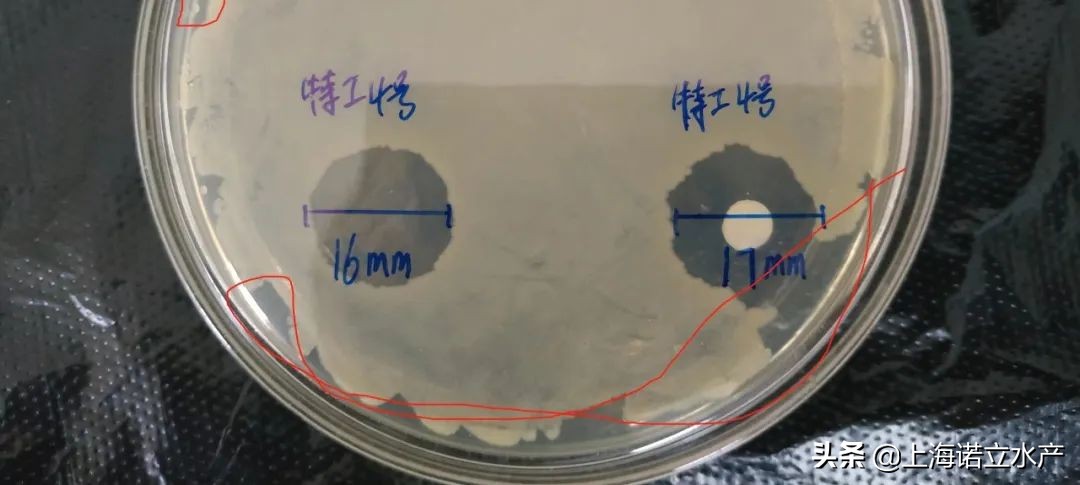
如何判断虾有没有弧菌了,为什么养虾弧菌越杀越多
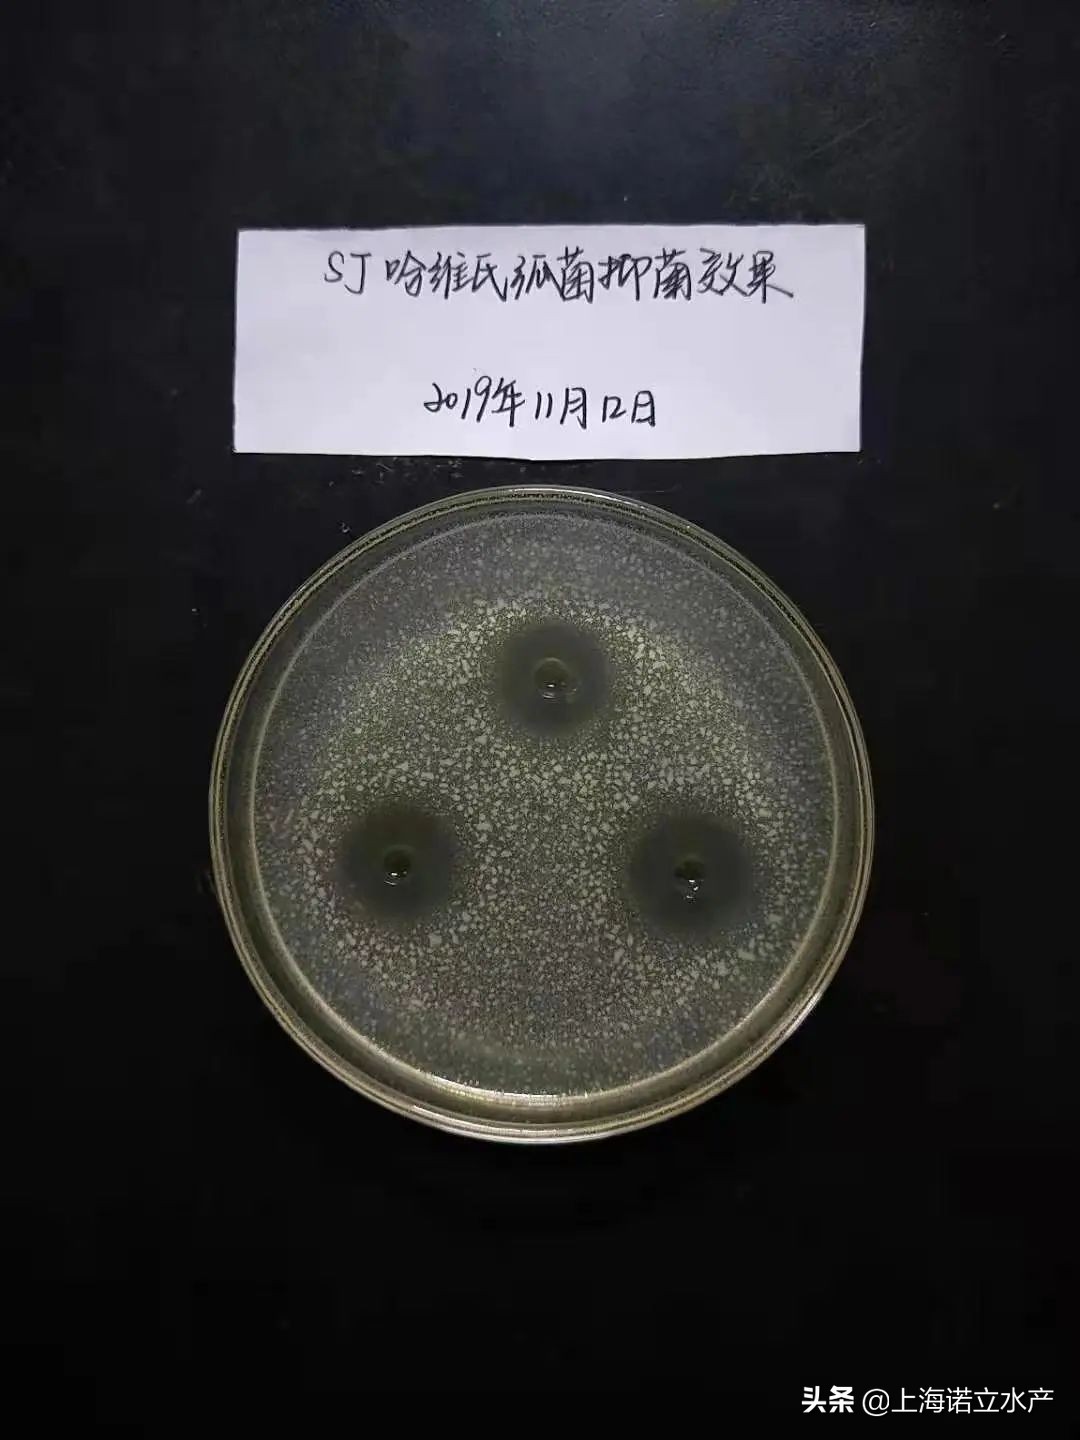
如何判断虾有没有弧菌了,为什么养虾弧菌越杀越多
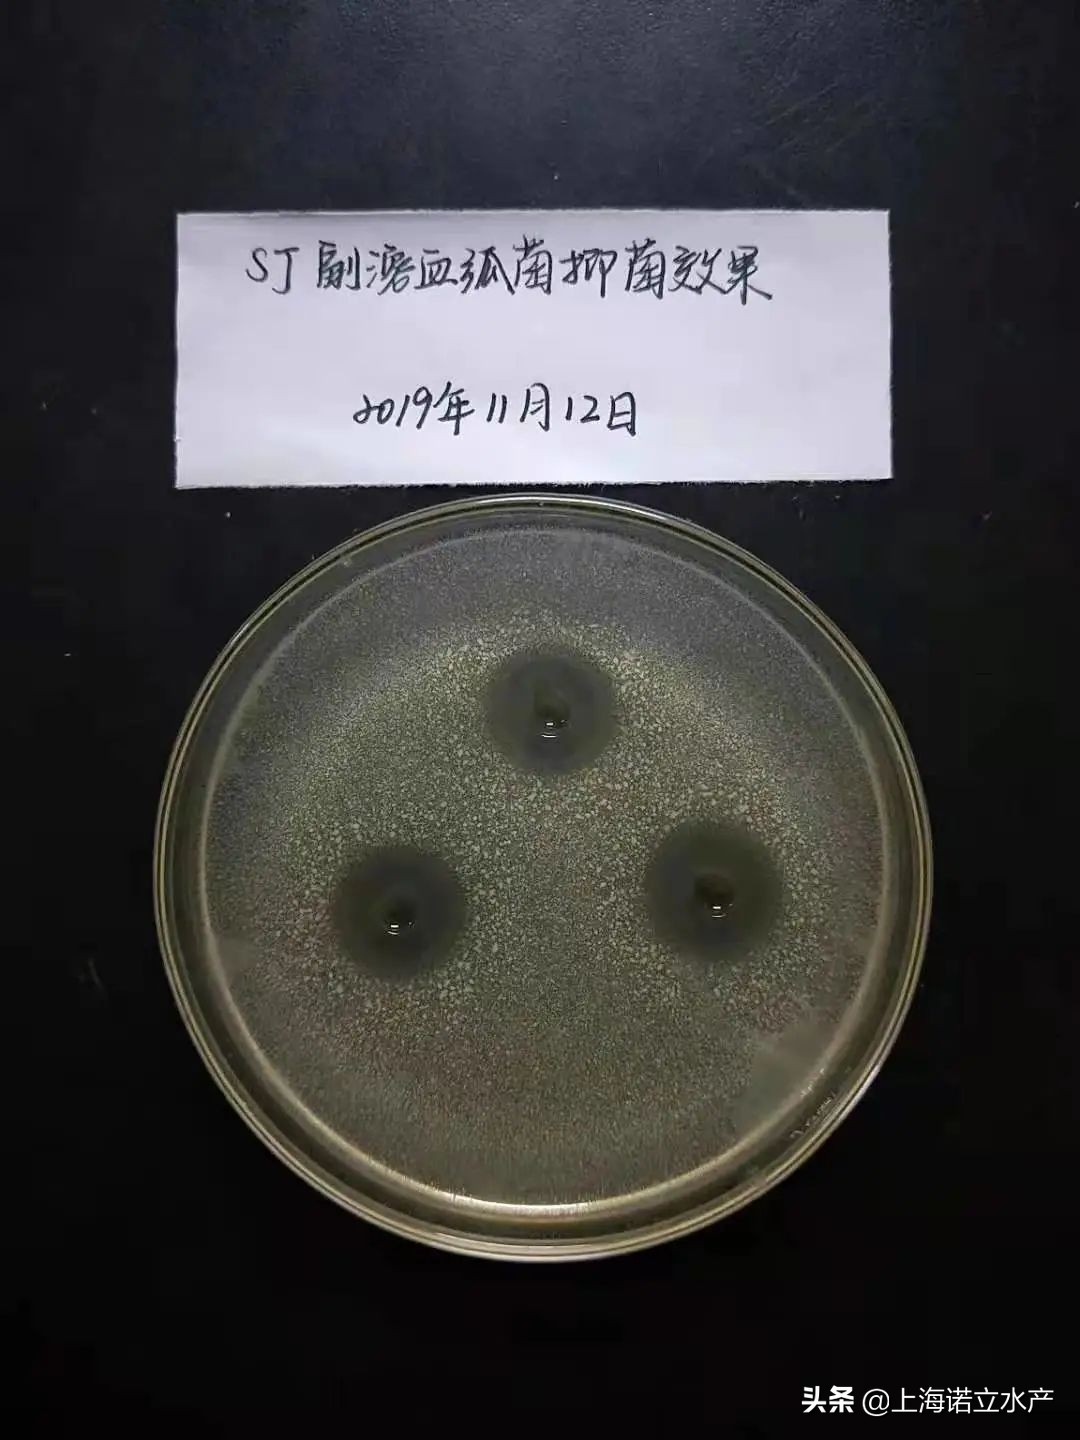
如何判断虾有没有弧菌了,为什么养虾弧菌越杀越多

弧菌是菌体短小,弯曲成弧形,尾部带一鞭毛的革兰氏阴性菌,是水产养殖中最常见的细菌性病原之一,水产养殖常见弧菌有 副溶血性弧菌、鳗弧菌、溶藻弧菌、哈维氏弧菌等 ,在TCBS培养基上体现的就是黄弧菌和绿弧菌。

一、弧菌病的特点
对虾弧菌病频发,以100-500头的对虾居多。
主要分以下三种情况:
1、症状轻者:部分对虾食线不清晰,肝胰脏颜色变淡;身体微红,鳃发黄,零星掉苗。
2、症状较重者:多数虾开始出现食线不清晰、断肠或空肠,肝胰腺发白,鳃发黄;多数池子提料台会发现数尾死虾,活虾摄食不佳,个别池子掉苗严重。
3
、症状严重者:多数池子都严重掉苗,病虾空肠空胃,部分虾肠道充满黄色脓液,鳃部发黄或腐烂,肝胰脏肿大、发白;病死虾清捞不及,活虾摄食不佳。

二、正确认识弧菌
弧菌是一类可引起肠道感染的细菌。弧菌属(弧菌科的1属)广泛分布于自然界,尤以水中为多,有100多种。致病弧菌会引发肠胃炎、食物中毒、霍乱、败血症等疾病。
事实上致病的弧菌很少,绝大多数弧菌是有益菌。引起水生生物致病的弧菌则更少。
水产养殖中弧菌病的危害已被广大养殖户公认,常见的致病弧菌有:副溶血弧菌、河弧菌、拟态弧菌、霍利斯弧菌、溶藻性弧菌、创伤弧菌、弗尼斯弧菌、溶藻弧菌、发光弧菌、费氏弧菌、鳝弧菌等。
三、造成对虾死亡的弧菌
涂布TCBS培养基显示:前两种情况下,水中有大量黄色弧菌,病虾或健康虾肝胰腺中有黄弧菌和绿弧菌存在,但黄弧菌居多。后一种情况下,水中已开始出现绿弧菌,病虾肝胰腺中大量出现绿弧菌。
四、弧菌病怎么防控
弧菌如此猖獗,我们该如何应对?
上海诺立生物从2019年联合上海噬菌体研究所李锦铨教授对噬菌体进行了全面的深入的研究,开发水产专用噬菌体,目前上海诺立拥有全国最全最大最先进的噬菌体毒株贮藏菌种库,我们的噬菌体具有噬菌体防盗技术和抗性防控技术。

在过去的三年里,上海诺立研发团队持续从广东、广西、福建、海南以及越南、泰国等弧菌高发地区收集水体样品,从中分离了超过180株致病菌,并每年从全国各地寄的水样中分离了100 多株,再依照FDA 的GRAS 认证要求,结合市场情况开发出了含有数株噬菌体的鸡尾酒制剂,专门针对南美白对虾开发出了“ 猎弧特工 ”系列高浓度烈性噬菌体。

强大的研发科研团队,主要来自英国剑桥大学,华中农业大学,武汉大学等,为噬菌体的研究和治疗水生动物养殖疾病提供了强有力的理论和技术支持,在噬菌体的研究上位居最前言。

噬菌体在细菌内能够产生数百个自己并裂解杀死细菌,繁殖速度快,杀菌效率高。噬菌体只能在细菌内存活和繁殖,在裂解细菌后进入环境中,若无相应的细菌存在,噬菌体就会自然消亡。

噬菌体可以“拌料内服+泼洒”,效果奇佳。泼洒可有效降低水体环境中的弧菌,保持水体正常生态环境。拌料饲喂,一方面可以进入肝胰腺和胃肠道定点清除有害菌,防止对机体的损伤;另一方面,噬菌体通过粪便进入水体仍可以继续杀灭水体内的有害菌。
研发团队刻苦攻坚将“ 耐热保护剂 ”镶嵌入产品,使得噬菌体可常温保存,解决了其不能常温储藏和运输的难题。另外研发团队还潜心匹配了多样性噬菌体,使其相互协作,从而形成了高浓度的烈性噬菌体。使得“ 猎弧特工系列 ”噬菌体这一天然的细菌天敌,更具备有特异性、靶向性,且不破坏水体环境和有益菌,颠覆了我们之前虾疾病防治的传统概念,猎弧特工系列产品进行敏感性测试,特别是猎弧特工3号和猎弧特工4号,可以实现对所分离细菌的裂解,对副溶血弧菌的裂解效果非常好。

出现了弧菌,首先要增强对虾体质,建议大家长期拌料上海诺立的“ 特免球蛋白
”从虾的本身来增强他的免疫系统和体质,但是健康虾即使携带弧菌,也可正常生长;其次避免养殖环境出现大的波动;再者定期检测弧菌,发现异常,及时采取措施,用上海诺立的猎弧噬菌体。

猎弧特工3号外泼,土塘3亩,高位池2亩,工厂化建议1.5到2个ppm,小棚建议2到3个棚,对于对虾体内的副溶血弧菌超标,我们可以通过拌料内服猎弧特工4号,一天两次,一共3到5天,之后停拌五天,后续在来一个循环,有效解决对虾体内副溶血弧菌问题,外泼加内服体内体外双向结合。
图文编辑:周 薇
爆品推荐

